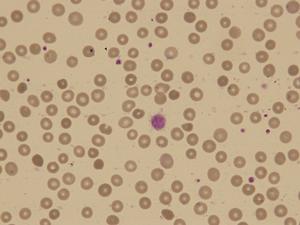
捐獻血小板會對身體產生哪些負面影響

在生活中我們難免會受傷會出現疾病的情況那么我們也就有可能會有用到血小板的需求但是血小板的獲取是需要人們捐獻的,但是現如今對于捐獻血小板的相關知識的普及力度并不足夠所以很多時候人們對于捐獻血小板的負面影響并不了解。
獻血小板的好處
1、適量獻血小板會使骨髓造血系統不斷受到激發,新鮮血細胞比例增高,血液粘稠度降低。
2、減少心腦血管病的發病率,并具有預防作用。
捐獻血小板的危害
3、隨著血液的排出,可以減少體內過多的鐵質,可以減少癌癥的發病率。
4、通過獻血可以稀釋血液,減輕動脈硬化的隱患。
5、促使血細胞生成,使骨髓保持活力。
6、解決醫院血量庫存緊張,幫助更多需要輸血的人。
獻血小板的壞處
獻血小板是一件非常有意義的事情,但是也希望準備去參與獻血的人們可以在了解自己的身體狀況及獻血相關的事項之后再做決定。
在有時準備不足,或是對于獻血沒有一個深入的了解時,獻血者在獻血過程中,可能會由于生理或者是心理因素導致以血容量急劇下降,植物神經功能紊亂為特征的綜合征。當血容量恢復或心理因素解除后,機體就會恢復正常。而在實際工作中,心理因素導致的獻血反應起碼占了80%左右,這與獻血員對獻血不了解,采血工作人員心理護理工作做得不足有很大關系。
在獻血之后,可能會出現心慌,頭暈,感冒,發燒等癥狀,此等癥狀在身體瘦弱,免疫力較低下的人群身上尤為明顯。
而在了解獻血的一系列相關事項之后決定去獻血的時候,一定要選擇大型的,正規的醫院,以避免一些在小型的獻血站因不衛生而引起的細菌的感染,雖然比例很小,但是并不是沒有先例。
雖然捐獻血小板是一件很正能量的事情但是對于人們來說捐獻血小板也對身體存在著一些負面影響所以我們要充分的進行了解,只有對于捐獻血小板的相關知識有了一定的了解之后我們才能做好捐獻血小板的相關準備把影響降低到最小。






